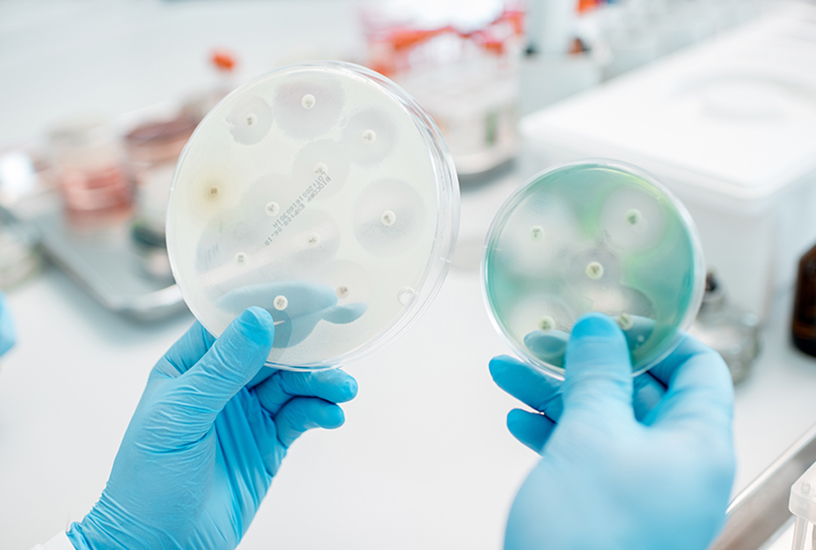
Doxycycline Antibacterial Activity | Shaanxi BLOOM Tech Co., Ltd Doxycycline Antibacterial Activity | Shaanxi BLOOM Tech Co., Ltd

Doxycycline, een tetracycline-antibioticum van de tweede- generatie, is sinds de introductie ervan in de jaren zestig een hoeksteen van antimicrobiële therapie. Verkrijgbaar in verschillende formuleringen, waaronder orale tabletten, capsules en injecteerbare oplossingen, biedt de poedervorm -vaak gebruikt voor bereidingen, veterinaire toepassingen en onderzoek- unieke voordelen op het gebied van flexibiliteit en biologische beschikbaarheid.
| Productnaam | Doxycycline poeder | Doxycycline-tabletten | Doxycycline-injectie | Doxycycline-capsules | Doxycyclinepasta | Doxycycline-druppels | |
| Producttype | Poeder | Tablet | Injectie | Capsules | Plakken | Druppels | |
| Productzuiverheid | >98% | >98% | >98% | >98% | >98% | >98% | |
| Productspecificaties | 10g;100g;1kg | Aanpasbaar | Aanpasbaar | Aanpasbaar | Aanpasbaar | Aanpasbaar | |
| Productvorm | Organische synthese | Aanpasbaar | Aanpasbaar | Aanpasbaar | Aanpasbaar | Aanpasbaar | |
|
|
||
| Certificaat van analyse | ||
| Samengestelde naam | Doxycycline | |
| CAS-nr. | 564-25-0 | |
| Hoeveelheid | 30 kg | |
| Fabrikant | Shaanxi BLOOM TECH Co., Ltd | |
| Kavelnr. | 20250625012 | |
| MFG | 28 juni 2025 | |
| EXP | 30 juni 2028 | |
| Structuur |
|
|
| Item | Enterprise-standaard | Analyse resultaat |
| Verschijning | Lichtgeel tot bruin | Conform |
| Watergehalte | Minder dan of gelijk aan 5,0% | 0.12% |
| Zware metalen | Pb Minder dan of gelijk aan 0,5 ppm | N.D. |
| Als Minder dan of gelijk aan 0,5 ppm | N.D. | |
| Hg Minder dan of gelijk aan 0,5 ppm | N.D. | |
| Cd Minder dan of gelijk aan 0,5 ppm | N.D. | |
| Zuiverheid (HPLC) | >98% | 99.26% |
| Enkele onzuiverheid | <0.8% | 0.16% |
| Totaal aantal microben | Minder dan of gelijk aan 750 cfu/g | 30 |
| E. Coli | Minder dan of gelijk aan 2 MPN/g | N.D. |
| Salmonella | N.D. | N.D. |
| Ethanol (door GC) | Minder dan of gelijk aan 5000 ppm | 100 ppm |
| Opslag | -80 graden, 2 jaar; -20 graden, 1 jaar (afgesloten opslag, weg van vocht) | |
|
|
||
|
|
||
| Shaanxi Chuzhan is een technologiebedrijf dat gespecialiseerd is in onderzoek en ontwikkeling, productie van chemicaliën en maatwerkdiensten voor apparatuur, en dat OEM/ODM-oplossingen voor de volledige- keten levert. We bieden flexibele volledige-procesdiensten op maat, van formuleonderzoek en -ontwikkeling tot apparatuurselectie, die allemaal diepgaand kunnen worden aangepast aan de eisen van de klant. Ondersteunt de volledige-cyclus van technische samenwerking, van kleinschalige-proeven, middelgrote-proeven tot grootschalige-productie, uitgerust met een professioneel technisch team om suggesties voor procesoptimalisatie te geven, en kan verpakkingslabels aanpassen aan de merkvereisten van klanten. | ||
Mechanisme van actie
Doxycycline oefent zijn primaire effecten uit via twee verschillende mechanismen:
Antibacteriële activiteit
Ribosomale remming: Doxycycline bindt zich aan de 30S-subeenheid van bacteriële ribosomen, waardoor de aanhechting van aminoacyl-tRNA wordt geblokkeerd en de eiwitsynthese wordt verstoord. Deze bacteriostatische werking remt de groei van Gram{3}}positieve (bijv. Staphylococcus aureus, Streptococcus pneumoniae) en Gram-negatieve bacteriën (bijv. Escherichia coli, Haemophilus influenzae), evenals van atypische pathogenen zoals Chlamydia trachomatis en Mycoplasma pneumoniae.
Verstoring van de biofilm: Uit onderzoek blijkt dat doxycycline bacteriële biofilms kan verzwakken, waardoor de werkzaamheid van andere antibiotica bij chronische infecties zoals longinfecties die verband houden met cystische fibrose- wordt vergroot.
Anti-Ontstekings- en immuunmodulerende effecten
Remming van matrixmetalloproteïnase (MMP): Doxycycline onderdrukt MMP's, enzymen die betrokken zijn bij weefselafbraak en ontsteking. Deze eigenschap wordt benut bij de behandeling van parodontitis, rosacea en reumatoïde artritis.
Cytokinemodulatie: Een lage- dosis doxycycline vermindert pro-inflammatoire cytokines (bijv. TNF- , IL-6), waardoor het nuttig is bij niet-infectieuze inflammatoire aandoeningen.
Chemische en farmacologische eigenschappen
Chemische structuur
Doxycycline is een semi{0}}synthetische tetracycline met de molecuulformule C₂₂H₂₄N₂O₈ en een molecuulgewicht van 462,44 g/mol. De structuur bestaat uit een naftaceenkern met vier- ringen met functionele groepen op posities 4, 5, 6 en 7, waaronder een dimethylaminogroep op C4, wat de lipofiliteit en weefselpenetratie ervan verbetert.
Mechanisme van antibacteriële werking
Doxycycline remt de bacteriële eiwitsynthese door te binden aan de 30S-ribosomale subeenheid, waardoor de hechting van aminoacyl-tRNA aan het mRNA--ribosoomcomplex wordt voorkomen. Deze werking is bacteriostatisch (stopt de groei van bacteriën) in plaats van bacteriedodend (doodt bacteriën), waardoor het effectief is tegen een breed scala aan micro-organismen, waaronder:
1) Gram-positieve bacteriën:Staphylococcus aureus, Streptococcus pneumoniae, Listeria monocytogenes.
2) Gram-negatieve bacteriën:Escherichia coli, Haemophilus influenzae, Neisseria gonorroe.
3) Atypische pathogenen:Mycoplasma pneumoniae, Chlamydia trachomatis, Legionella pneumophila.
4) Rickettsiae:Rickettsia rickettsii(Rocky Mountain gevlekte koorts).
5) Spirocheten:Borrelia burgdorferi(ziekte van Lyme),Treponema pallidum(syfilis).
Anti-Ontstekings- en immuunmodulerende effecten
Naast de antimicrobiële eigenschappen oefent doxycycline ook anti-inflammatoire en immunomodulerende effecten uit door:
Het remmen van matrixmetalloproteïnasen (MMP's), enzymen die betrokken zijn bij weefselafbraak (bijvoorbeeld bij parodontitis en artritis).
Onderdrukking van pro-inflammatoire cytokines (bijv. IL-6, TNF- ) bij aandoeningen zoals rosacea en reumatoïde artritis.
Vermindering van oxidatieve stress door vrije radicalen op te vangen.
Farmacokinetiek van Doxycycline-poeder
Na reconstitutie vertoont doxycyclinepoeder een gunstige farmacokinetiek:
Absorptie: ~90–100% biologische beschikbaarheid bij orale inname met water; niet beïnvloed door voedsel (in tegenstelling tot oudere tetracyclines).
Distributie: Wijd verspreid in weefsels, waaronder hersenvocht (CSF), synoviale vloeistof en prostaat.
Halfwaardetijd-: 16-22 uur, waarbij een eenmalige- dagelijkse dosering mogelijk is.
Metabolisme: Minimaal levermetabolisme; voornamelijk onveranderd uitgescheiden in de ontlasting (40%) en urine (20-30%).
Interactie tussen doxycycline en leverenzyminductoren
Interactiemechanisme
Het metabolisme van doxycycline in het lichaam is voornamelijk afhankelijk van het hepatische cytochroom P450-enzymsysteem (CYP450), vooral CYP3A4 en CYP2C8. Deze enzymen zetten doxycycline om in inactieve of minder actieve metabolieten door oxidatie, hydroxylering en andere reacties, die uiteindelijk via gal en urine worden uitgescheiden. Leverenzyminductoren (zoals fenobarbital, fenytoïne, carbamazepine en rifampicine) kunnen het metabolisme van doxycycline versnellen via de volgende mechanismen:
Verbeterde enzymactiviteit: Hepatische geneesmiddelenzyminductoren activeren direct de genexpressie van CYP450-enzymen, waardoor de synthese van de enzymen toeneemt. Fenytoïne kan de CYP3A4-activiteit bijvoorbeeld 2-3 keer verhogen, wat resulteert in een verkorting van de halfwaardetijd van doxycycline van 14-22 uur naar ongeveer 7 uur.

Veranderingen in de enzymstabiliteit: Bepaalde inductoren (zoals rifampicine) verbeteren de stabiliteit van CYP450-enzymen door de intracellulaire omgeving van hepatocyten te veranderen, waardoor hun werkingsduur wordt verlengd.
Competitieve binding: De inductor kan de actieve plaats van het CYP450-enzym innemen, waardoor indirect de metabolische transformatie van doxycycline wordt bevorderd.
Klinische impact
Het versnellende effect van leverenzyminductoren op het metabolisme van doxycycline leidt direct tot een verlaging van de plasmaconcentratie, wat op zijn beurt de volgende klinische problemen veroorzaakt:

Verminderde antibacteriële werkzaamheid: Bij de behandeling van luchtweginfecties kan de plasmaconcentratie van doxycycline met meer dan 50% worden verlaagd bij patiënten die worden behandeld met fenytoïne, wat leidt tot een afname van de bacteriële klaring en een verlenging van het ziekteverloop. Uit een onderzoek bij patiënten met chronische bronchitis bleek bijvoorbeeld dat na combinatietherapie met fenytoïne de minimale remmende concentratie (MIC)-waarde van doxycycline tegen Streptococcus pneumoniae tweemaal zo hoog was, en dat het percentage mislukte behandelingen steeg van 12% naar 34%.
Verhoogd risico op geneesmiddelresistentie: Onvoldoende plasmaconcentratie van het geneesmiddel kan bacteriële resistentie veroorzaken. Als bij de behandeling van syfilis de plasmaconcentratie van doxycycline lager is dan 0,5 µg/ml, neemt de klaringssnelheid van spirocheten aanzienlijk af, wat gevoelig is voor serofast (aanhoudende positieve serologische respons).
Onevenwicht in de risico's van bijwerkingen: Ter compensatie van onvoldoende werkzaamheid kunnen artsen genoodzaakt zijn de dosering van doxycycline te verhogen, wat kan leiden tot gastro-intestinale reacties (zoals misselijkheid en braken), lichtgevoeligheidsreacties (zoals zonnebrand-zoals huiduitslag) en hepatotoxiciteit (zoals verhoogde transaminasen).
Klinische toepassingen

Infectieziekten
1) Luchtweginfecties
Community-verworven pneumonie (CAP): effectief tegenMycoplasma, Chlamydophila, EnLegionella.
Bronchitis: alternatief voor bèta-lactams bij penicilline-allergische patiënten.
Tuberculose: wordt gebruikt bij behandelingen die multiresistent zijn- tegen meerdere geneesmiddelen (MDR-TB).
2) Infecties van de huid en weke delen
Acne vulgaris: VermindertPropionibacterium acneskolonisatie en ontsteking.
Cellulitis: effectief tegenStafylokokkenEnStreptokokkensoort.
Lepra: eerste-behandeling voor paucibacillaire en multibacillaire vormen.
3) Seksueel overdraagbare infecties (soa's)
Chlamydia trachomatis: voorkeursbehandeling voor ongecompliceerde genitale infecties (100 mg tweemaal daags gedurende 7 dagen).
Gonorroe: Gebruikt in combinatie met ceftriaxon vanwege stijgende resistentie.
Syfilis: alternatief voor penicilline-allergische patiënten (hoewel minder effectief dan benzathinepenicilline).
4) Vector-overdraagbare ziekten
Ziekte van Lyme: vroege gelokaliseerde of verspreide infectie (100 mg tweemaal daags gedurende 10-21 dagen).
Malariaprofylaxe: effectief tegenPlasmodium falciparumin chloroquine-resistente gebieden (100 mg per dag vanaf 1-2 dagen vóór de reis).
Babesiose: Gebruikt met clindamycine voor ernstige gevallen.


Niet-besmettelijke aandoeningen
1) Parodontitis
Subantimicrobiële-dosis doxycycline (tweemaal daags 20 mg) remt MMP's, waardoor de diepte van de parodontale pocket en bloeding wordt verminderd.
2) Rosacea
Doxycycline 40 mg met gereguleerde-afgifte (ORACEA®) vermindert ontstekingslaesies met 60-70% bij matige- tot- ernstige rosacea.
3) Reumatologische aandoeningen
Reactieve artritis: Vermindert synoviale ontsteking.
Sarcoïdose: Kan de vorming van granulomen verminderen via immunomodulatie.
Veterinaire toepassingen
Veel voorkomende infecties bij dieren
1) Vogelgeneeskunde
Ornithose: Doxycyclinepoeder (20% oplosbaar) gemengd met drinkwater in een dosis van 5 g/gallon gedurende 7-10 dagenChlamydia psittacibij papegaaien en duiven.
Mycoplasmose: Chronische luchtweginfecties bij pluimvee kunnen worden behandeld met 10-20 mg/kg lichaamsgewicht per dag.
2) Gezelschapsdieren
Ziekte van Lyme bij honden: 5 mg/kg tweemaal daags gedurende 30 dagen na-tekenbeet.
Infecties van de bovenste luchtwegen bij katten: 2,5–5 mg/kg per dag gedurende 7–14 dagenChlamydia felisofBordetella bronchiseptica.
3) Vee
Leptospirose bij rundvee: 2,2 mg/kg per dag gedurende 7 dagen voorkomt abortusstormen.
Varkensdysenterie: 10 mg/kg per dag in het voer gedurende 10–14 dagen controlesBrachyspira hyodysenteriae.
Toedieningsmethoden
1) Orale suspensie: Doxycycline poeder wordt gemengd met water of melkvervangers voor een gemakkelijke dosering bij vogels en pasgeborenen.
2) Actuele toepassingen: Zalven met 3% doxycycline behandelen ooginfecties bij paarden en honden.
3) Injecteerbare oplossingen: Gereserveerd voor ernstige gevallen (bijv. bloedvergiftiging), hoewel orale routes de voorkeur hebben vanwege de kosten en veiligheid.
Voordelen van Doxycycline-poeder
Flexibiliteit in dosering en toediening:
1) Dosering op maat: Ideaal voor pediatrische patiënten (bijv. 1–2 mg/kg/dag) of voor patiënten die nauwkeurige titratie vereisen.
2) Enterale voedingssondes: Kan worden gemengd met water voor toediening aan patiënten die geen tabletten kunnen doorslikken.
3) Veterinair gebruik: Gemakkelijk te meten voor grote dieren (bijvoorbeeld paarden, runderen) waar vloeibare formuleringen onpraktisch zijn.
Kosten-Effectiviteit:Generiek doxycyclinepoeder is goedkoop, waardoor het toegankelijk is in lage- en midden-inkomenslanden.
Stabiliteit en houdbaarheid:Wanneer doxycyclinepoeder op de juiste manier wordt bewaard (droog, koel, weg van licht), behoudt het zijn kracht tot 5 jaar, in tegenstelling tot sommige vloeibare formuleringen die sneller afbreken.
Bijwerkingen en veiligheidsprofiel

Vaak voorkomende bijwerkingen
1) Gastro-intestinaal: Misselijkheid (10-15% van de patiënten), braken en diarree komen vaak voor, en worden vaak verzacht door het medicijn met voedsel in te nemen.
2) Lichtgevoeligheid: tot 30% van de gebruikers ervaart zonnebrand-achtige reacties, waarvoor zonnebrandcrème en beschermende kleding nodig zijn.
3) Schimmelinfecties: Doxycycline verstoort de vaginale flora, waardoor het risico op candida-overgroei toeneemt.
Ernstige reacties
1) Intracraniale hypertensie: Deze aandoening is zeldzaam maar ernstig en veroorzaakt ernstige hoofdpijn en gezichtsstoornissen. Een onderzoek uit 2004 bracht langdurig doxycyclinegebruik in verband met pseudotumor cerebri, vooral bij vrouwen in de vruchtbare leeftijd.
2) Stevens-Johnson-syndroom: een levens-bedreigende blaaruitslag gemeld in<0.1% of cases, often requiring hospitalization.
3) Tandverkleuring: Permanente verkleuring komt voor bij 3-6% van de kinderen die worden blootgesteld tijdens de tandontwikkeling, zoals gedocumenteerd in een casusrapport uit 2006.


Geneesmiddelinteracties
Doxycycline heeft een wisselwerking met:
1) Antacida/supplementen: Calcium, magnesium en ijzer verminderen de absorptie als ze gelijktijdig worden ingenomen. Patiënten wordt geadviseerd de doseringen met een interval van 2 uur te spreiden.
2) Warfarine: Doxycycline versterkt de antistollingseffecten, waardoor het bloedingsrisico toeneemt.
3) Retinoïden: Gelijktijdig gebruik met isotretinoïne (voor acne) verhoogt het risico op intracraniale hypertensie.
Opkomend onderzoek en toekomstige richtingen
Oncologie
1) MMP-remming: de anti-metastatische effecten van doxycycline worden getest in onderzoeken naar borstkanker en glioblastomen.
2) Senolytische therapie: vroege studies suggereren dat het verouderde cellen kan opruimen, waardoor veroudering-gerelateerde ziekten worden vertraagd.
Neurodegeneratieve ziekten
Ziekte van Alzheimer: Doxycycline verminderde de amyloïde-bèta-plaques met 60% in muismodellen, wat aanleiding gaf tot Fase II-onderzoeken bij mensen.
Antivirale toepassingen
1) Dengue-virus: In vitro-onderzoeken tonen aan dat doxycycline de virale replicatie remt door de proteasen van de gastheercellen te blokkeren.
2) SARS-CoV-2: een onderzoek uit 2020 rapporteerde een verminderde virale last bij COVID-19-patiënten, hoewel grotere onderzoeken nodig zijn.
Doxycyclinepoeder blijft een essentieel hulpmiddel bij het bestrijden van bacteriële infecties bij verschillende soorten, waarbij de werkzaamheid in evenwicht wordt gebracht met een beheersbaar veiligheidsprofiel. De veelzijdigheid ervan-van de behandeling van luchtwegaandoeningen bij vogels tot het voorkomen van bioterrorisme-gerelateerde bedreigingen- onderstreept het belang ervan in de moderne geneeskunde. Verstandig gebruik is echter essentieel om risico's zoals resistentie en bijwerkingen te beperken. Zowel patiënten als dierenartsen moeten zich houden aan de doseringsrichtlijnen, letten op bijwerkingen en onnodige langdurige therapie- vermijden. Nu onderzoek steeds nieuwe toepassingen aan het licht brengt (bijvoorbeeld MMP-remming bij chronische wonden), staat de rol van doxycycline in de gezondheidszorg op het punt zich uit te breiden, op voorwaarde dat het met precisie en voorzichtigheid wordt toegepast.
Veelgestelde vragen
Welke infecties zal doxycycline opruimen?
+
-
Doxycycline wordt voornamelijk gebruikt voor de behandeling van bacteriële infecties, waaronder enkele:
urineweginfecties (UTI's)
seksueel overdraagbare aandoeningen (soa's)
infecties van de borst.
tandvleesinfecties.
Welke twee ziekten kan doxycycline voorkomen?
+
-
Doxycycline (of kortweg "doxy") is een veel voorkomend antibioticum. Recent onderzoek toont aan dat het innemen van doxycycline binnen 3 dagen (of 72 uur) na de seks sommige mensen kan helpen de kans op syfilis, chlamydia en, in sommige onderzoeken, gonorroe te verkleinen. Deze preventiestrategie wordt doxy PEP genoemd.
Is doxycycline een medicijn met een hoog risico?
+
-
De rubrieken 'Waarschuwingen en voorzorgsmaatregelen' in de bijsluiters van doxycycline waarschuwen gebruikers voor een aantal risico's: blijvende tandverkleuring en hypoplasie van het glazuur tijdens de tandontwikkeling bij een kind als het in de laatste helft van de zwangerschap van de moeder wordt ingenomen.
Populaire tags: doxycyclinepoeder, leveranciers, fabrikanten, fabriek, groothandel, kopen, prijs, bulk, te koop









